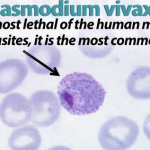

Lo sciopero dei medici previsto per oggi è stato rinviato, ma permane lo stato di agitazione; assemblee su tutti i luoghi di lavoro per discutere del problema che più sta minando la tenuta del SSN: la carenza di personale medico!
Dagli infermieri invece il silenzio più assoluto!
Coloro che per primi dovrebbero alzare la testa per rivendicare un problema con cui convivono da anni fin troppo rassegnati, continuano supinamente ad alimentare questo sistema, rientrando sui propri riposi, derogando costantemente ai propri diritti pur di “mandare avanti il reparto” o “per il bene del paziente”.
Agli infermieri serve uscire dall’individualismo del proprio metro quadro di reparto tramite una lettura di sistema che consente di collegare i problemi del nostro piccolo con i problemi a livello sistemico perché ciò che succede nelle nostre realtà è il riflesso di un progetto politico più ampio che riusciamo a cogliere allargando lo zoom sul nostro presente.
Simone Garilli giovane esponente di un partito sovranista emergente, il FSI – Fronte Sovranista Italiano, ci aiuta ad allargare lo zoom, così da prendere coscienza della natura profonda dei nostri problemi. In occasione del seminario “Idee per ricostruire l’Italia” organizzato dal CPR – Centro Studi sulla Costituzione e sulla Prima Repubblica in collaborazione con il Fronte Sovranista Italiano, Garilli ricostruisce i passaggi politici che si sono susseguiti a partire dal 1992, anno del Trattato di Maastricht e del D.Lgs 502, smascherando il vero significato politico delle riforme che hanno mutato il volto della sanità italiana attraverso parole d’ordine imposte dalla classe dominante neo-liberale: sussidiarietà, federalismo, autonomia fiscale, depoliticizzazione, efficienza e concorrenza.
Considerato il rapporto inevitabilmente conflittuale fra sanità pubblica (diritto alla salute) e Trattati Europei, si analizzeranno quelle parole chiave prima e dopo l’avvento dei Trattati, per capire come la classe dominante neo-liberale, invadendo le nostre vite, ha forgiato il nostro modo di pensare ed operare.
Prima dei trattati, il principio di sussidiarietà o solidarietà veniva esercitato dallo Stato centrale per aiutare le regioni in difficoltà a diminuire le diseguaglianze e le sperequazioni. Dopo i trattati il principio di sussidiarietà viene esercitato da parte dello Stato per “aiutare” le regioni che non rientrano nei tetti di spesa (con tagli al personale e blocco delle assunzioni e turnover) a sostituire gli assessori alla sanità scelti democraticamente con un commissario “ad acta” cioè adatto…alle prescrizioni di austerità dei Trattati. L’opera di depoliticizzazione degli stati sovrani nazionali da parte dell’UE, funziona sempre alla medesima maniera: quando uno Stato o una regione esce dai bilanci prescritti, arriva la mano tecnica a “salvarci” e la tecnocrazia si sostituisce alla democrazia.
Il federalismo in sanità è stato possibile perché nei primi anni 2000 alla forte la spinta della Lega Nord aveva fatto eco l’ideologia dell’intera classe dirigente neo-liberale secondo la quale il nord doveva essere potenziato perché partner diretto dell’UE, mentre si rimaneva incuranti dell’arretratezza storica/politica e culturale del sud. Risultato: aumento delle diseguaglianze! Ecco perché i colleghi del sud si lamentano della totale assenza di OSS rispetto al nord, tutto torna!
L’aumento delle differenze tra regioni è accentuato dall’autonomia fiscale. Le regioni si sono avvalse di questo strumento per rientrare negli standard dei costi per la sanità, quando gli standard, prima dei Trattati erano calcolati in base alla spesa storica (cioè quanto una regione aveva speso l’anno prima per rispondere ai bisogni di salute della propria comunità). Dopo i Trattati erano calcolati in base ai tetti di spesa massimi delle regioni più virtuose, più ricche. Conseguenza: aumento delle tasse per i cittadini e aumento della disomogeneità tra regioni nell’offerta di salute.
Anche il parametro dell’efficienza del SSN si è trasformato. Prima dei trattati esso era un rapporto tra il prodotto ottenuto e le risorse impegnate. Dopo i Trattati e con l’avvento dell’ euro, l’efficienza si è trasformata nella possibilità di far galleggiare il sistema con i minor investimenti possibili. Tanto più è efficiente il sistema quanto più si riesce a de-finanziarlo. Il definanziamento del FSN comincia già dal 1992 con l’aziendalizzazione.
Anche se negli anni il valore nominale dell’importo destinato al FSN è aumentato, di fatto rimane inferiore rispetto ai bisogni di salute…quindi se aumenta il valore nominale ma inferiormente ai bisogni e all’inflazione, si va contro la natura incrementale della spesa sanitaria e si ottiene un de-finanziamento progressivo. L’avvento dell’Austerità vera e propria nel 2012, porterà per la prima volta alla diminuzione anche del valore nominale dell’importo della spesa sanitaria. Ma quei tagli alla sanità erano necessari? Mario Monti, che dall’informazione mainstream viene elevato a salvatore della patria, lo sapeva che il nostro SSN spende molto meno di altri paesi in rapporto al PIL. E allora perché? Perché la nostra politica non ascolta i bisogni dei cittadini ma si limita ad essere “mero esecutore” (ci dice qualcosa questo termine?) degli ordini provenienti dall’alto.
Con un sistema pubblico perennemente de-finanziato, a crescere sono gli erogatori privati di salute. Ed ecco che la “concorrenza” inteso come valore che anima il mercato globale delle merci e dei capitali, adesso pervade anche il campo della salute. Il principio della libera concorrenza giustifica anche la possibilità del più forte di imporsi sul più debole. È quello che succede adesso nella nostra sanità tra erogatore privato (forte) che si impone sull’erogatore pubblico (debole).
In conclusione per non continuare a vivere come schiavi amanti delle proprie catene, come nel mito della caverna di Platone, urge scovare le cause più profonde dei nostri problemi. Dopo aver costruito una coscienza collettiva del nostro malessere, per salvaguardare la conquista sociale più importante, riappropriarci di quote di sovranità diventa oggi un imperativo per la difesa della nostra libertà di professionisti e di cittadini.
Avanti, ci libereremo!
Raffaele Varvara

Lascia un commento